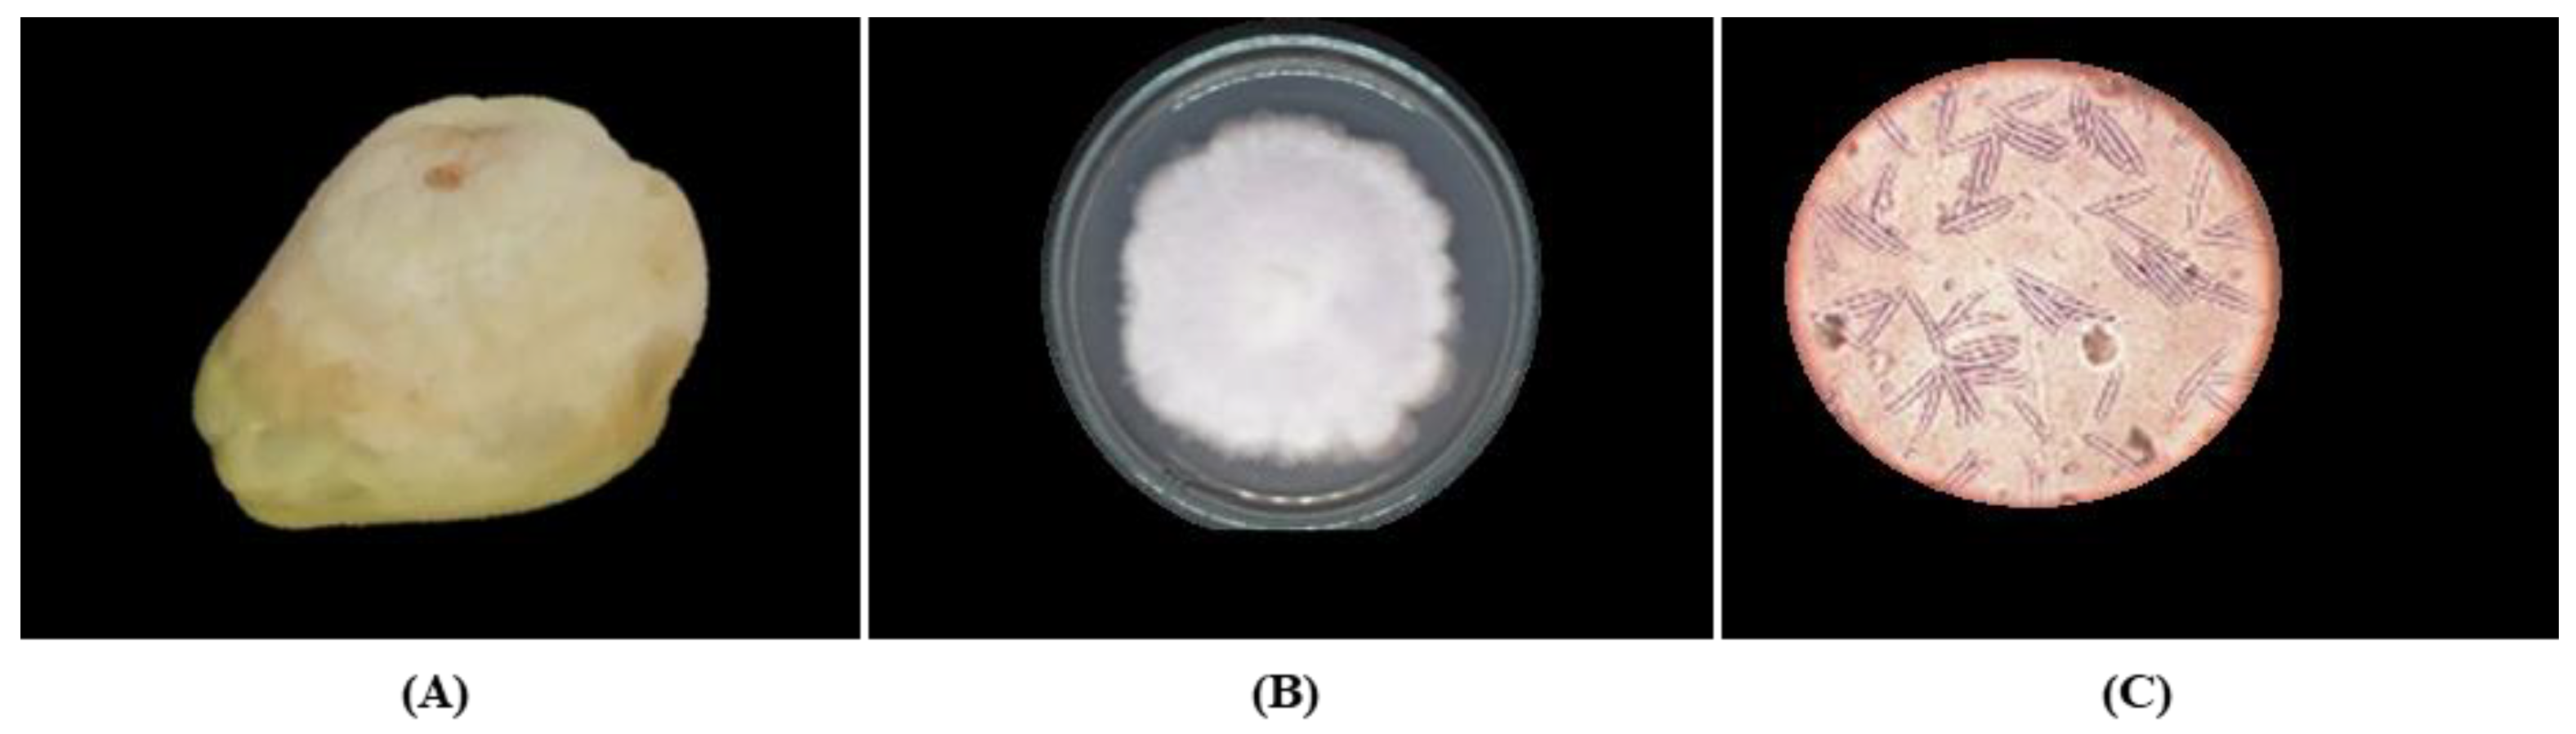

Plant Extracts Control In Vitro Growth of Disease-Causing Fungi in Chayote
Abstract
1. Introduction
2. Results
2.1. Isolation and Identification of Fungal Strains
2.2. Effectiveness of Plant Extracts
3. Discussion
4. Materials and Methods
4.1. Plant Material
4.2. Isolation and Identification of Fungal Strains
4.3. Plant Extracts
4.4. In Vitro Evaluation of Plant Extracts on Postharvest Fungi
4.5. Statistical Analysis
5. Conclusions
Supplementary Materials
Author Contributions
Funding
Data Availability Statement
Acknowledgments
Conflicts of Interest
References
- Cadena-Iñiguez, J.; Avendaño-Arrazate, C.H.; Aguirre-Medina, J.F.; Arévalo-Galarza, M.L.; Cisneros-Solano, V.M.; Campos-Rojas, E. El chayote (Sechium edule (Jacq.) Sw., importante recurso fitogenético mesoamericano. Agroproductividad 2010, 3, 26–34. [Google Scholar]
- Servicio de Información Agroalimentaria y Pesquera (SIAP). Available online: https://nube.siap.gob.mx/cierreagricola/ (accessed on 12 February 2021).
- Agrios, G.N. Fitopatología, 2nd ed.; Ed. Limusa: Mexico City, Mexico, 2008; 838p. [Google Scholar]
- Arévalo-Galarza, M.L.; Cadena-Íñiguez, J.; Romero-Velazquez, S.D.; Tlapal-Bolaños, B. Rescatando y Aprovechando los Recursos Fitogenéticos de Mesoamérica; Chayote Fruit: Manejo Postcosecha; Grupo Interdisciplinario de Investigación en Sechium edule en México, A.C. (GISeM), Colegio de Postgraduados: Montecillo, Mexico, 2011; Volume 3. [Google Scholar]
- del Puerto Rodríguez, A.M.; Suárez Tamayo, S.; Palacio Estrada, D.E. Efectos de los plaguicidas sobre el ambiente y la salud. Rev. Cuba. Hig. Epidemiol 2014, 52, 372–387. [Google Scholar]
- Rodríguez, P.A.T.; Ramírez, A.M.A.; Bautista, B.A.; Cruz, T.A.; Rivero, D. Actividad antifúngica de extractos de Acacia farnesiana sobre el crecimiento in vitro de Fusarium oxysporum f. sp. Lycopersici. UDO Ag. 2012, 12, 91–96. [Google Scholar]
- Villa-Martínez, A.; Pérez-Leal, R.; Morales-Morales, H.A.; Basurto-Sotelo, M.; Soto-Parra, J.M.; Martínez-Escudero, E. Situación actual en el control de Fusarium spp. y evaluación de la actividad antifúngica de extractos vegetales. Acta Agron. 2015, 64, 194–205. [Google Scholar] [CrossRef]
- Ávalos Gavilla, A.; Morales Romero, L.; Rojas Moya, X. Potencial antifúngico de extractos vegetales sobre el crecimiento in vitro de Colletotrichum gloeosporioides Penz. Agric. Tropical. 2019, 5, 39–45. [Google Scholar]
- Abou-Jawdah, Y.; Sobh, H.; Salameh, A. Antimycotic activities of selected plant flora, growing wild in Lebanon, against phytopathogenic fungi. J. Agric. Food Chem. 2002, 50, 3208–3213. [Google Scholar] [CrossRef] [PubMed]
- Daferera, D.J.; Ziogas, B.N.; Polissiou, M.G. The effectiveness of plant essential oils on the growth of Botrytis cinerea, Fusarium sp. and Clavibacter michiganensis subsp. michiganensis. Crop. Prot. 2003, 22, 39–44. [Google Scholar] [CrossRef]
- Orozco-Sánchez, F.; Rodríguez-Monroy, M. Cultivos de células en suspensión de Azadirachta indica para la producción de un bioinsecticida. Rev. Mex. Ing. Quim. 2007, 6, 251–258. [Google Scholar]
- Ghosh, V.; Sugumar, S.; Mukherjee, A.; Chandrasekaran, N. Aceites de neem (Azadirachta indica). In Essential Oils in Food Preservation, Flavor and Safety; Ghosh, V., Sugumar, S., Mukherjee, A., Chandrasekaran, N., Eds.; Centre for Nanobiotechnology, VIT University: Vellore Tamil Nadu, India, 2016; pp. 593–599. [Google Scholar]
- Montes-Belmont, R.; Carvajal, M. Control of Aspergillus flavus in maize with plant essential oils and their components. J. Food Prot. 2009, 61, 616–619. [Google Scholar] [CrossRef] [PubMed]
- Cosentino, S.; Tuberoso, C.I.C.; Pisano, B.; Satta, M.; Mascia, V.; Arzedi, E.; Palmas, F. In-Vitro antimicrobial activity and chemical composition of Sardinian Thymus essential oils. Lett. Appl. Microbiol. 2002, 29, 130–135. [Google Scholar] [CrossRef]
- Dorman, H.D.R.; Deans, S.G. Antimicrobial agents from plants: Antibacterial activity of plant volatile oils. J. Appl. Microbiol. 2000, 88, 308–316. [Google Scholar] [CrossRef]
- Bullerman, L.B.; Lieu, Y.; Seier, S.A. Inhibition of growth and aflatoxin production by cinnamon and clove oils, cinnamic aldehyde and eugenol. J. Food Sci. 1977, 42, 1107–1109. [Google Scholar] [CrossRef]
- Soliman, K.M.; Badeaa, R.I. Effect of oil extracted from some medicinal plants on different mycotoxigenic fungi. Food Chem. Toxicol. 2002, 40, 1669–1675. [Google Scholar] [CrossRef] [PubMed]
- Velluti, A.; Sanchis, V.; Ramos, A.J.; Egido, J.; Marin, S. Inhibitory effect of cinnamon, clove, lemongrass, oregano and palmarose essential oils on growth and fumonisin B1 production by Fusarium proliferatum in maize grain. Int. J. Food Microbiol. 2003, 89, 145–154. [Google Scholar] [CrossRef] [PubMed]
- Cáceres Rueda de León, I.; Colorado Vargas, R.; Salas-Muñoz, E.; Muñoz Castellanos, L.N.; Hernández-Ochoa, L. Antifungal Activity in vitro of the Aqueous Extracts of Spice’s Against Fusarium oxysporum, Alternaria alternata, Geotrichum candidum, Trichoderma spp., Penicillum digitatum and Aspergillus niger. Rev. Mex. Fitopatol. 2013, 31, 105–112. [Google Scholar]
- Ochoa-Fuentes, Y.M.; Cerna Chávez, E.; Landeros Flores, J.; Hernández Camacho, S.; Delgado Ortiz, J.C. Evaluación in vitro de la actividad antifúngica de cuatro extractos vegetales metanólicos para el control de tres especies de Fusarium spp. Phyton-Int. J. Exp. Bot. 2012, 81, 69–73. [Google Scholar]
- Ramírez-González, S.I.; López Báez, O.; Espinosa Zaragoza, S.; Wong Villarreal, A. Actividad antifúngica de hidrodestilados y aceites sobre Alternaria solani, Fusarium oxysporum y Colletotrichum gloesporioides. Rev. Mex. Cienc. Agric. 2016, 7, 1879–1891. [Google Scholar] [CrossRef]
- Pazmiño-Miranda, P.; Velástegui-Espín, G.P.; Curay, S.; Yánez-Yánez, W.; Vásquez, C. Effect of hydro-ethanolic extracts of cinnamon (Cinnamomum zeylanicum Blume) and common horsetail (Equisetum arvense L.) on incidence and severity of Botrytis cinerea on strawberry. J. Selva Andin. Biosph. 2017, 5, 29–38. [Google Scholar] [CrossRef]
- Kowalska, J.; Tyburski, J.; Krzymińska, J.; Jakubowska, M. Cinnamon powder: An in vitro and in vivo evaluation of antifungal and plant growth promoting activity. Eur. J. Plant Pathol. 2020, 156, 237–243. [Google Scholar] [CrossRef]
- Dai, J.; Yaylayan, V.; Vijaya, G.S.; Pare, J. Extraction and colorimetric determination of azadirachtin-related limonoids in neem seed kernel. J. Agric. Food Chem. 1999, 47, 3738–3742. [Google Scholar] [CrossRef]
- Dubey, R.C.; Kumar, R. Efficacy of Azadirachtin and fungicides on growth and survival of sclerotia of Macrophomina phaseolina causing charcoal rot in Soyabean. Indian Phytopathol. 2003, 56, 216–217. [Google Scholar]
- Bolívar, K.; Sanabria, M.E.; Rodríguez, D.; Camacaro, M.; Ulacio, D.; Cumana, L.J.; Crescente, O. Potencial efecto fungicida de extractos vegetales en el desarrollo in vitro del hongo Colletotrichum gloeosporioides (Penz.) Penz y Sacc. y de la antracnosis en frutos de mango. UDO Ag. 2009, 9, 175–181. [Google Scholar]
- Landero Valenzuela, N.; Nieto-Ángel, D.; Téliz Ortiz, D.; Alatorre Rosas, R.; Orozco Santos, M.; Ortiz García, C.F. Potencial antifúngico de extractos de cuatro especies vegetales sobre el crecimiento de Colletotrichum gloeosporioides en papaya (Carica papaya) en poscosecha. Rev. Venez. Cienc. Tecnol. Aliment. 2013, 4, 47–62. [Google Scholar]
- Rawat, K.; Sahoo, U.K.; Hegde, N.; Kumar, A. Effectiveness of Neem (Azadirachta indica A. Juss) Oil against Decay Fungi. Sci. Technol. J. 2017, 5, 48–51. [Google Scholar] [CrossRef]
- Lal, M.C.; Chaudhary, S.; Rawal, S.; Sharma, S.; Kumar, M.; Chakrabarti, S.K. Evaluation of bio-agents and neem based products against late blight disease (Phytophthora infestans) of potato. Indian Phytopathol. 2021, 74, 181–187. [Google Scholar] [CrossRef]
- Ramos, C.; González, V.; Soto, M.; Engleman, E.; Rodríguez, D. Variación en contenido de azadiractina en frutos de margosa durante su desarrollo. Rev. Fitotec. Mex. 2004, 27, 81–85. [Google Scholar] [CrossRef]
- Niaz, I.; Sitara, U.; Kazmi, S.A.R.; Qadri, S. Comparison of antifungal properties of neem seed oil collected from different parts of Pakistan. Pak. J. Bot. 2008, 40, 403–408. [Google Scholar]
- Arellano-Gómez, C.S.V.G. Biochemical and physiological changes during ripening of black sapote fruit (Diospyros digyna Jacq.). Agrociencia 2005, 39, 173–181. [Google Scholar]
- Pino, J.A.; Ortiz-Vázquez, E.; Sauri-Duch, E.; Cuevas-Glory, L. Characterization of aroma-active compounds in black Zapote (Diospyros digyna Jacq.). Acta Aliment. 2014, 43, 547–552. [Google Scholar] [CrossRef]
- Rauf, A.; Uddin, G.; Patel, S.; Khan, A.; Halim, S.A.; Bawazeer, S.; Ahmad, K.; Muhammad, N.; Mubarak, M.S. Diospyros, an under-utilized, multi-purpose plant genus: A review. Biomed. Pharmacother. 2017, 91, 714–730. [Google Scholar] [CrossRef]
- Dzoyem, J.P.; Tangmouo, J.G.; Lontsi, D.; Etoa, F.X.; Lohoue, P.J. In Vitro antifungal activity of extract and plumbagin from the stem bark of Diospyros crassiflora Hiern (Ebenaceae). Phytother. Res. 2007, 21, 671–674. [Google Scholar] [CrossRef]
- Surapuram, V.; Setzer, W.N.; McFeeters, R.L.; McFeeters, H. Antifungal activity of plant extracts against Aspergillus niger and Rhizopus stolonifer. Nat. Prod. Commun. 2014, 9, 1603. [Google Scholar] [CrossRef]
- Ramírez-Briones, E.; Rodríguez-Macías, R.; Salcedo-Pérez, E.; Ramírez-Chávez, E.; Molina-Torres, J.; Tiessen, A.; Ordaz-Ortiz, J.; Martínez-Gallardo, N.; Délano-Frier, J.P.; Zañudo-Hernández, J. Seasonal changes in the metabolic profiles and biological activity in leaves of Diospyros digyna and D. rekoi “Zapote” trees. Plants 2019, 8, 449. [Google Scholar] [CrossRef] [PubMed]
- Montes, B.R. Evaluación de plantas antifúngicas y su potencial aplicación en la fitosanidad. In Memorias del VI Simposio Nacional Sobre Sustancias Vegetales y Minerales en el Combate de Plagas; Plantas: Biotecnología, Agronomía, Nutrición; COFAA-IPN: Acapulco, México, 2000; pp. 111–121. [Google Scholar]
- Romero-Velazquez, S.D.; Tlapal-Bolaños, B.; Cadena-Iñiguez, J.; Nieto-Ángel, D.; Arévalo-Galarza, M.L. Hongos causantes de enfermedades postcosecha en chayote (Sechium edule (Jacq.) Sw.) y su control in vitro. Agron. Costarric. 2015, 39, 19–32. [Google Scholar] [CrossRef]
- Panizo, M.M.; Reviákina, V.; Montes, W.; González, G. Mantenimiento y preservación de hongos en agua destilada y aceite mineral. RSVM 2005, 25, 35–40. [Google Scholar]
- Cuadrado Cano, B.S.; Vélez Castro, M.T.; Infante Jiménez, C. Biotecnología: De la Teoría a la Práctica; Editorial Universitaria, Universidad de Cartagena: Cartagena, Colombia, 2015. [Google Scholar]
- Barnett, H.I.; Hunter, B. Illustrated Genera of Imperfect Fungi, 4th ed.; The American Phytopathologycal Society: St. Paul, MN, USA, 1986. [Google Scholar]
- Olguín-Hernandez, G.; Cisneros-Solano, V.M.; Acosta-Ramos, M. Hongos asociados a síntomas de enfermedades en chayote (Sechium edule (Jacq.) Sw) y estrategias de manejo. Agroproductividad 2011, 4, 16–23. [Google Scholar]
- Olguín-Hernández, G.; Valdovinos-Ponce, G.; Cadena-Iñiguez, J.; Arévalo-Galarza, M.L. Etiología de la Marchitez de Plantas de Chayote (Sechium edule) en el Estado de Veracruz. Rev. Mex. Fitopatol. 2013, 31, 161–169. [Google Scholar]
- Olguín-Hernandez, G.; Cadena-Iñiguez, J.; Arevalo-Galarza, M.L.; Valdez-Carrazco, J.; Rosas-Saito, G.H.; Tlapal-Bolaños, B. Organismos Asociados al Chayote; Colegio de Postgraduados: Montecillo, Mexico, 2017. [Google Scholar]
- Barrera-Necha, L.L.; García-Barrera, L.J. Antifungal activity of essential oils and their compounds on the growth of Fusarium sp. isolate from papaya (Carica papaya). UDO Ag. 2008, 8, 33–41. [Google Scholar]
- Pandey, D.K.; Tripathi, N.N.; Tripathi, R.D.; Dixit, S.N. Fungitoxic and phytotoxic properties of the essential oil of Hyptis suaveolens. J. Plant. Dis. Prot. 1982, 89, 344–349. [Google Scholar]

| Treatment | Concentration (ppm) | Fusarium oxysporum | Fusarium solani | Geotrichum sp. | Phytophthora capsici |
|---|---|---|---|---|---|
| (% Inhibition) | |||||
| Cinnamon oil | 300 | 100.00 a | 100.00 a | 100.00 a | 100.00 a |
| 350 | 100.00 a | 100.00 a | 100.00 a | 100.00 a | |
| 400 | 100.00 a | 100.00 a | 100.00 a | 100.00 a | |
| Sapote extract | 300 | 4.70 hi | 2.71 i | 3.94 hi | 7.88 ghi |
| 350 | 7.75 ghi | 8.17 ghi | 7.67 ghi | 10.19 gh | |
| 400 | 26.07 def | 21.95 ef | 28.61 e | 24.28 def | |
| Neem oil | 300 | 24.69 def | 39.50 c | 13.34 g | 51.87 b |
| 350 | 22.56 def | 40.70 c | 22.33 def | 56.09 b | |
| 400 | 27.82 de | 42.29 c | 20.96 f | 53.31 b | |
Disclaimer/Publisher’s Note: The statements, opinions and data contained in all publications are solely those of the individual author(s) and contributor(s) and not of MDPI and/or the editor(s). MDPI and/or the editor(s) disclaim responsibility for any injury to people or property resulting from any ideas, methods, instructions or products referred to in the content. |
© 2023 by the authors. Licensee MDPI, Basel, Switzerland. This article is an open access article distributed under the terms and conditions of the Creative Commons Attribution (CC BY) license (https://creativecommons.org/licenses/by/4.0/).
Share and Cite
García-Ramírez, E.; Contreras-Oliva, A.; Salinas-Ruiz, J.; Hernández-Ramírez, G.; Spinoso-Castillo, J.L.; Colmenares Cuevas, S.I. Plant Extracts Control In Vitro Growth of Disease-Causing Fungi in Chayote. Plants 2023, 12, 1800. https://doi.org/10.3390/plants12091800
García-Ramírez E, Contreras-Oliva A, Salinas-Ruiz J, Hernández-Ramírez G, Spinoso-Castillo JL, Colmenares Cuevas SI. Plant Extracts Control In Vitro Growth of Disease-Causing Fungi in Chayote. Plants. 2023; 12(9):1800. https://doi.org/10.3390/plants12091800
Chicago/Turabian StyleGarcía-Ramírez, Edgar, Adriana Contreras-Oliva, Josafhat Salinas-Ruiz, Gabriela Hernández-Ramírez, José Luis Spinoso-Castillo, and Saira Itzel Colmenares Cuevas. 2023. "Plant Extracts Control In Vitro Growth of Disease-Causing Fungi in Chayote" Plants 12, no. 9: 1800. https://doi.org/10.3390/plants12091800
APA StyleGarcía-Ramírez, E., Contreras-Oliva, A., Salinas-Ruiz, J., Hernández-Ramírez, G., Spinoso-Castillo, J. L., & Colmenares Cuevas, S. I. (2023). Plant Extracts Control In Vitro Growth of Disease-Causing Fungi in Chayote. Plants, 12(9), 1800. https://doi.org/10.3390/plants12091800

